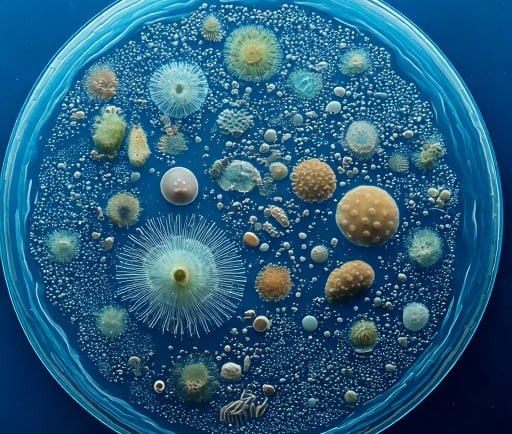
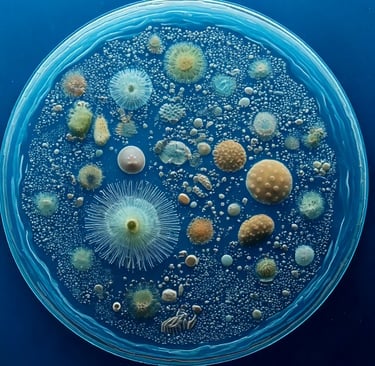

The Microcosm of Ocean Life: Understanding the Richness of a Single Drop of Water

Introduction to Oceanic Microorganisms
The vastness of the world’s oceans encompasses more than just majestic creatures and breathtaking landscapes; it contains hidden treasures of microscopic life. A single drop of ocean water is teeming with an array of microorganisms, making it a fascinating ecosystem. These microscopic organisms, including plankton, zooplankton, phytoplankton, and protozoans, play critical roles in the ocean's food web.
The Role of Plankton in the Marine Ecosystem
Plankton, a term that encompasses a diverse group of organisms, serves as the foundation of the oceanic food web. Phytoplankton, the photosynthetic form of plankton, converts sunlight into energy, providing food for numerous marine species. Zooplankton, the animal counterpart, preys on phytoplankton and serves as a food source for larger marine animals. This delicate balance within the aquatic ecosystem exemplifies the intricate interdependence of oceanic life.
Importance of Microorganisms in Ocean Health
Microorganisms such as protozoans are not only integral to the ocean's food web but also play a significant role in the health of marine environments. They help in nutrient cycling, breaking down organic matter, and supporting overall marine biodiversity. The diverse array of life found within a single drop of ocean water highlights the importance of preserving these ecosystems, as they are fundamental to the planetary health and sustainability of oceans.
Understanding the rich tapestry of life within ocean water, even at a microscale, is crucial for appreciating the role that these organisms have in the broader marine ecosystem. Protecting our oceans means recognizing the importance of microorganisms that underpin the health and longevity of marine habitats. The diversity of life found in just a drop of seawater inspires a sense of wonder and responsibility to preserve these vital ecosystems for future generations.
